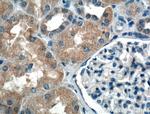
PDK4 Antibody in Immunohistochemistry (Paraffin) (IHC (P))

Search
Proteintech
PDK4 Polyclonal Antibody
{{$productOrderCtrl.translations['antibody.pdp.commerceCard.promotion.promotions']}}
{{$productOrderCtrl.translations['antibody.pdp.commerceCard.promotion.viewpromo']}}
{{$productOrderCtrl.translations['antibody.pdp.commerceCard.promotion.promocode']}}: {{promo.promoCode}} {{promo.promoTitle}} {{promo.promoDescription}}. {{$productOrderCtrl.translations['antibody.pdp.commerceCard.promotion.learnmore']}}
产品信息
12949-1-AP
种属反应
已发表种属
宿主/亚型
分类
类型
抗原
偶联物
形式
浓度
规格
纯化类型
保存液
内含物
保存条件
运输条件
产品详细信息
Immunogen sequence: LPVRLANIL KEIDILPTQL VNTSSVQLVK SWYIQSLMDL VEFHEKSPDD QKALSDFVDT LIKVRNRHHN VVPTMAQGII EYKDACTVDP VTNQNLQYFL DRFYMNRIST RMLMNQHILI FSDSQTGNPS HIGSIDPNCD VVAVVQDAFE CSRMLCDQYY LSSPELKLTQ VNGKFPDQPI HIVYVPSHLH HMLFELFKNA MRATVEHQEN QPSLTPIEVI VVLGKEDLTI KISDRGGGVP LRIIDRLFSY TYSTAPTPVM DNSRNAPLAG FGYGLPISRL YAKYFQGDLN LYSLSGYGTD AIIYLKALSS ESIEKLPVFN KSAFKHYQMS SEADDWCIPS REPKNLAKEV AM (61-412 aa encoded by BC040239)
靶标信息
PDK4 (PDHK4), along with the other PDHKs, regulates glucose metabolism by phosphorylating the E1 alpha subunit of the mitochondrial pyruvate dehydrogenase complex. Inhibition of PDHKs is viewed as a potential therapeutic treatment for type II diabetes. This protein is located in the matrix of the mitrochondria and it's expression is regulated by glucocorticoids, retinoic acid and insulin. PDK4 inhibits the mitochondrial pyruvate dehydrogenase complex by phosphorylation of the E1 alpha subunit, thus contributing to the regulation of glucose metabolism.
仅用于科研。不用于诊断过程。未经明确授权不得转售。
生物信息学
蛋白别名: [Pyruvate dehydrogenase (acetyl-transferring)] kinase isozyme 4, mitochondrial; [Pyruvate dehydrogenase [lipoamide]] kinase isozyme 4, mitochondrial; kinase isozyme 4; lipoamide; pyruvate dehydrogenase; pyruvate dehydrogenase kinase 4; Pyruvate dehydrogenase kinase isoform 4; pyruvate dehydrogenase kinase, isoenzyme 4; pyruvate dehydrogenase kinase, isozyme 4; pyruvate dehydrogenase, lipoamide, kinase isozyme 4, mitochondrial; pyruvate dehydrogenate kinase 4; unnamed protein product
基因别名: AV005916; PDHK4; PDK4
UniProt ID: (Human) Q16654, (Rat) O54937, (Mouse) O70571
Entrez Gene ID: (Human) 5166, (Rat) 89813, (Mouse) 27273